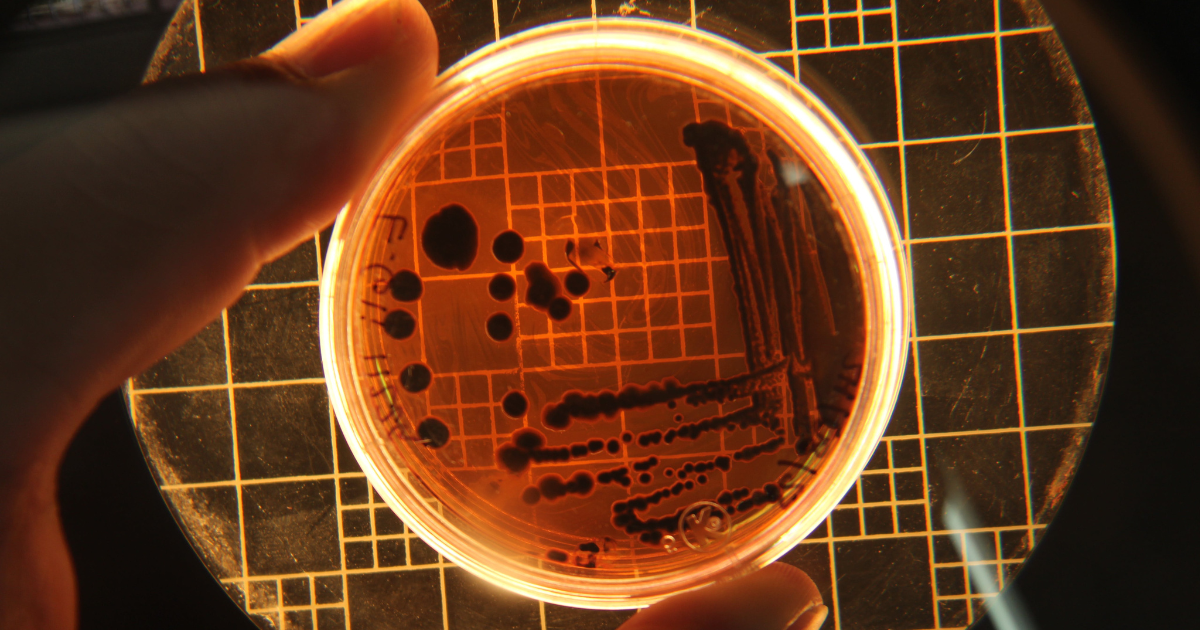
cultivo bacterias

Guía para conocer los microorganismos que dan vida a los suelos y aseguran el futuro agrícola
El suelo es el medio natural compuesto por minerales, materia orgánica, aire y agua. Provee de elemento hídrico, soporte y nutrientes a las plantas. Gracias a él, los humanos obtenemos un 98,8 % del total de las calorías que consumimos.
También sirve como hogar para una gran cantidad de seres vivos que no se ven a simple vista, entre los que destacan bacterias, hongos, virus, arqueas, protozoos, algas y nematodos. Los más estudiados debido a las funciones que realizan son las bacterias, los hongos y, en menor medida, las arqueas.
Estos minúsculos habitantes determinan el estado microbiológico de los suelos y les aportan múltiples beneficios. Su ausencia o escasez implica menos energía, menos agua y menos vida, lo que da sentido al auge de las experiencias agroregenerativas. Unas prácticas que buscan devolverle al suelo condiciones vitales para garantizar un medio agrario más ecológico y económicamente viable.
Los microorganismos se encargan de descomponer la materia orgánica y participan en el reciclaje y fijación de algunos nutrientes (nitrógeno, fósforo y potasio, entre otros).
Otra de sus funciones consiste en agrupar el suelo en terrones conocidos como agregados, que mejoran la retención de agua y la aireación. Además, promueven el crecimiento de cultivos y los protegen del ataque de plagas y enfermedades.
De la siembra y conteo a la secuenciación del ADN microbiano
El estudio de los microorganismos del suelo nace a mediados del siglo XIX. La siembra y conteo en placa, método microbiológico para estimar el número de microorganismos viables en una muestra, es una de las primeras técnicas y la más utilizada hasta la actualidad. No obstante, solo se han podido cultivar de este modo alrededor del 50 % de los microorganismos existentes.
En la década de los 70 del siglo XX se desarrolló una metodología que cuantifica la respiración del suelo. Esta técnica mide el dióxido de carbono que liberan los microorganismos como resultado de la degradación de materia orgánica. A partir de los estudios derivados, fueron sentadas las bases de lo que más tarde se ha conocido como “ecología microbiana”.
A la par, se desarrolló otra metodología que registra la actividad enzimática. Sirve como indicador de la presencia de microorganismos porque permite contabilizar los tipos de enzimas liberadas como consecuencia de la degradación de los materiales orgánicos.
Los avances más significativos surgen en los años 90 del siglo pasado con el desarrollo de las metodologías basadas en la extracción de ADN microbiano y su posterior secuenciación e identificación. Gracias a ellas, resulta posible identificar los microorganismos directamente del ambiente natural y conocer sus aportes al entorno.
Un tercio de los suelos sufren degradación
Según datos de la Organización de las Naciones Unidas para la Alimentación y la Agricultura (FAO), al menos el 33 % de los suelos de todo el planeta presentan algún nivel de degradación, ya sea leve, moderado o grave.
La principal razón de esta degradación tiene que ver con el hombre y su afán para producir más y mejores alimentos, que den respuesta a la demanda de una población en aumento constante.
Concretamente, la agroindustria impacta por el manejo del suelo, el uso excesivo de productos químicos (fertilizantes, herbicidas, insecticidas etc.) y la tendencia a favorecer la siembra de un solo tipo de cultivo (monocultivos).
Las malas prácticas han ocasionado diferentes afectaciones: pérdida de materia orgánica, erosión, suelos más salinos, cambios en el pH y contaminación de fuentes de agua. Estas afectaciones disminuyen el contenido de microorganismos del suelo y, a su vez, provocan una disminución en la fertilidad. El resultado es la reducción paulatina del rendimiento de cultivos, la degradación del suelo y el peligro para la seguridad alimentaria.
Textura, pH y temperatura
Dichas afectaciones modifican las características físicas y químicas del suelo que interactúan con los microorganismos, moldeando el crecimiento o disminución de especies. Estudios demuestran que la textura, el pH, la temperatura y los nutrientes son los principales factores que inciden en la presencia de microorganismos en el suelo.
La textura condiciona el crecimiento de microorganismos. Un suelo poco poroso reduce la cantidad de agua que puede retener y el oxígeno disponible. Además, la cantidad de nutrientes aumenta o disminuye según su composición mineral.
Otro elemento que limita el crecimiento de microorganismos es el pH o potencial de hidrógeno, que mide la acidez o alcalinidad. El valor del pH en el suelo oscila entre 3,5 (muy ácido) a 9,5 (muy alcalino). Los suelos muy ácidos (<5,5) tienden a presentar cantidades elevadas y tóxicas de aluminio y manganeso. Los suelos muy alcalinos (>8,5) pueden dispersarse.
El pH del suelo depende de la composición mineral, el tiempo de formación y la cantidad de lluvia. La modificación del pH, aunque sea mínima, provoca la pérdida de microorganismos debido a la adaptación al nuevo factor.
Por otro lado, el cambio climático provocado por la actividad humana ha modificado la temperatura del planeta. Un cambio que afecta al crecimiento de microorganismos y a la fertilidad de los suelos.
Microorganismos, humus y simbiosis
En el suelo, los microorganismos son los encargados de descomponer la materia orgánica, esparciendo sustancias conocidas como enzimas.
Este proceso genera una tierra negra llamada humus que mejora la textura, la retención de agua y la nutrición de las plantas. También hace posible el ciclo de nutrientes (carbono, nitrógeno, fósforo, potasio), que desencadena la transformación de la materia y la consecuente fertilización del suelo.
Las plantas y los microorganismos conviven cercanamente y comparten beneficios. Las plantas liberan sustancias por la raíz (exudados) que atraen microorganismos para realizar una unión benéfica llamada simbiosis. En esta unión, las plantas le dan alimento al microorganismo (azúcares) y los microorganismos acercan agua y nutrientes a la planta, incluso la protegen de plagas y enfermedades.
¿Cómo afecta la disminución de microorganismos en el suelo?
La pérdida de microorganismos provoca deterioro en los suelos, lo que afecta negativamente al rendimiento de cultivos.
Existe el riesgo de un aumento de la incidencia de plagas y enfermedades en los cultivos debido a la falta de microorganismos benéficos, así como por la ausencia de sus asociaciones simbióticas. Es el caso de aquellas que hacen solubles algunos nutrientes (micorrizas) o facilitan la descomposición (saprofitos), por mencionar algunas.
Estas situaciones limitan también el secuestro de carbono al disminuir la actividad biológica. Un hecho que implica mayor contaminación en muchos ambientes naturales, ya sean suelo, agua o aire.
¿Quiénes y de qué manera están actuando?
Organizaciones internaciones como la FAO y la Convención Marco de las Naciones Unidas sobre el Cambio Climático, a través de las denominadas Conferencias de las Partes, han propuesto acciones para revertir la degradación del suelo y favorecer el aumento de los microorganismos.
Por su parte el Departamento de Agricultura de los Estados Unidos (USDA) promueve a través de diversos programas la sustentabilidad agrícola que involucra el cuidado del suelo.
Otro tanto realizan asociaciones sin fines de lucro, como Kiss the Ground, una iniciativa que coloca el cuidado del suelo y la importancia de los microorganismos en el centro de la estrategia para revertir el cambio climático y garantizar la seguridad alimentaria. Su mensaje se está dando a conocer a través de un documental narrado por el conocido actor y activista Woody Harrelson.
Dentro de las acciones que promueven estas instituciones, destacan la agricultura con labranza mínima o cero labranza, que permite el desarrollo de microorganismos. También gana adeptos la agricultura de asociación, que consiste en una vuelta a los sistemas de agricultura tradicional, como la milpa mexicana, que producen más de un cultivo a la vez en el mismo suelo. Esta práctica concentra diversidad de plantas y un mayor contenido de microorganismos, lo que se traduce en una menor incidencia de plagas.
La agricultura orgánica, que recurre al uso de fertilizantes orgánicos como la composta y de productos biológicos a partir de microorganismos, representa otra opción.
Faltan más conocimientos y recursos para entender los procesos y financiar las nuevas tecnologías que permitan desarrollar estas acciones con la máxima eficacia. Pero la divulgación de la importancia del suelo y sus microorganismos contribuye sin duda a avanzar hacia un mundo agrario más seguro y sostenible.![]()
Mariano Angel Valdivia Dávila, Ciencias agrícolas y biotecnología, Universidad de Guadalajara
Este artículo fue publicado originalmente en The Conversation. Lea el original.